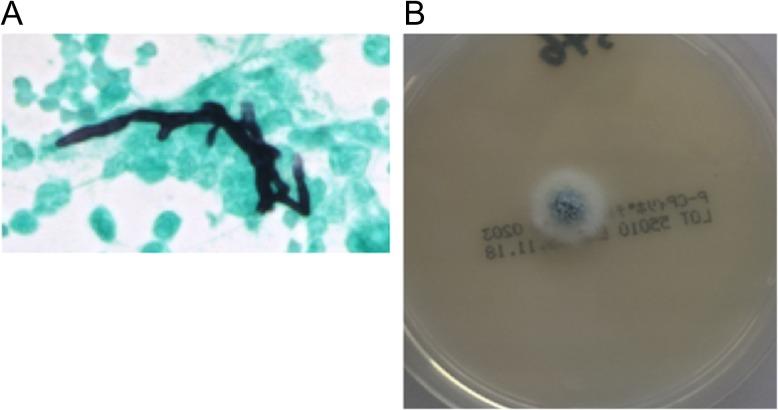
https://cdn.ncbi.nlm.nih.gov/pmc/blobs/a6c2/6380532/915781bb7309/omy126f03.jpg

慢性肺曲霉病可能通过变应性支气管肺曲霉病导致嗜酸性肉芽肿性多血管炎。
Chronic pulmonary aspergillosis may cause eosinophilic granulomatosis with polyangiitis via allergic bronchopulmonary aspergillosis.
作者信息
Harada Masanori, Imokawa Shiro, Miwa Satoru, Nihashi Fumiya, Aono Yuya, Amano Yusuke, Uto Tomohiro, Sato Jun, Suda Takafumi
机构信息
Department of Respirology, Iwata City Hospital, Iwata, Japan.
Second Department of Internal Medicine, Hamamatsu University School of Medicine, Hamamatsu, Japan.
出版信息
Oxf Med Case Reports. 2019 Feb 16;2019(2):omy126. doi: 10.1093/omcr/omy126. eCollection 2019 Feb.
An 84-year-old man visited our hospital with a prolonged productive cough. Chest computed tomography showed a thick wall cavity and bilateral consolidations. Laboratory findings revealed peripheral blood eosinophilia, increased total IgE and elevated myeloperoxidase anti-neutrophil cytoplasmic antibody. Specific IgE and IgG antibodies and an immediate skin reaction against showed positive results. The histological findings of the lung parenchyma were compatible with eosinophilic pneumonia and bronchial biopsy showed eosinophilic vasculitis. Bronchoalveolar lavage fluid culture yielded . These results met the diagnosis criteria for both allergic bronchopulmonary aspergillosis (ABPA) and eosinophilic granulomatosis with polyangiitis (EGPA). This case thus suggests that might be a pathogen common to both diseases, and prolonged exposure to in some patients with ABPA may promote progression to EGPA.
一名84岁男性因长期咳痰前来我院就诊。胸部计算机断层扫描显示有厚壁空洞和双侧实变。实验室检查结果显示外周血嗜酸性粒细胞增多、总IgE升高以及髓过氧化物酶抗中性粒细胞胞浆抗体升高。针对特定物质的特异性IgE和IgG抗体以及即刻皮肤反应呈阳性结果。肺实质的组织学检查结果符合嗜酸性粒细胞性肺炎,支气管活检显示嗜酸性血管炎。支气管肺泡灌洗 fluid culture yielded(此处原文有误,无法准确翻译)。这些结果符合变应性支气管肺曲霉病(ABPA)和嗜酸性肉芽肿性多血管炎(EGPA)的诊断标准。因此,该病例提示某种物质(此处原文有误,无法准确翻译)可能是这两种疾病的共同病原体,并且在一些ABPA患者中长时间接触该物质可能会促进疾病进展为EGPA。